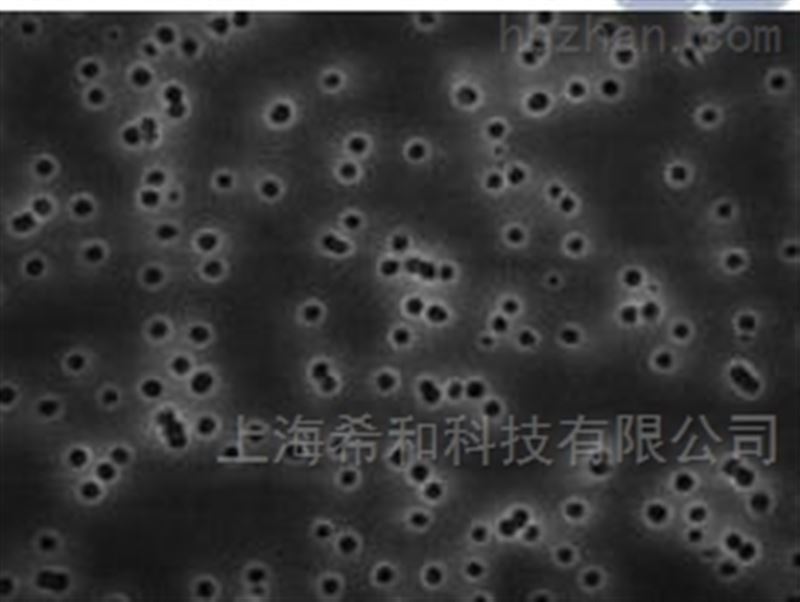

当前位置:首页 > 产品中心 > MILLIPORE 表面过滤膜 > ISOPORE聚碳酸酯 > HTBP04700MILLIPORE聚碳酸酯0.4微米孔径过滤膜-黑色

产品分类
Product classification详细介绍
Isopore 表面滤膜是在聚碳酸酯表面径迹蚀刻而成,推荐用于所有需要通过光学或电子显微镜技术对空气中的污染物及其它颗粒进行观察分析时使用。 Isopore 表面滤膜具有光滑的,像玻璃一样的表面,可以进行清晰的样品观察
| Price List Line Item Number | Price List UOM | Item Description |
| HTBP01300 | ISOPORE POLYCARB .4UM BK PL 13MM 100/PK | |
| HTBP02500 | PK | ISOPORE POLYCARB .4UM BK PL 25MM 100/PK |
| HTBP04700 | PK | ISOPORE POLYCARB .4UM BK PL 47MM 100/PK |
产品咨询